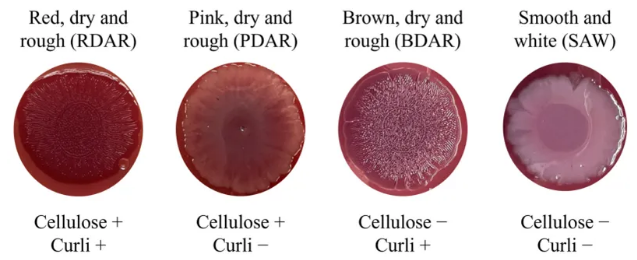

沙门氏菌病是全球范围内最值得关注的食源性疾病之一,不仅是造成重大社会经济损失的主要诱因,更对人类健康、民生福祉及医疗卫生保健系统构成持续性威胁。该疾病由沙门氏菌属 (Salmonella spp.) 引发,这是一种普遍存在于家畜体内的革兰氏阴性肠杆菌。根据欧洲食品安全局 (EFSA) 数据,2023年婴儿沙门氏菌 (Salmonella Infantis) 血清型是人类沙门氏菌病中第四常见的高频致病血清型。婴儿沙门氏菌因携带pESI等抗药性质粒并具备生物膜形成能力,其防控面临严峻挑战。在此背景下,噬菌体疗法作为传统抗菌剂的替代策略日益受到重视。本研究通过体外实验系统评估了噬菌体作为生物消毒剂在不同环境条件下对家禽行业相关婴儿沙门氏菌生物膜的清除效能,旨在探讨其在实际应用中的潜力。
文章内容
1. 婴儿沙门氏菌生物膜形成能力筛选及生物膜表征
本研究首先对21株婴儿沙门氏菌野生分离株的生物膜形成能力进行了系统筛选与表征。刚果红琼脂 (CRA) 平板涂布实验结果表明,在25 ℃培养条件下,90.48%的菌株能够分泌胞外聚合物 (EPS),其中76.19%表现为产卷曲菌毛的BDAR型,9.52%为同时产纤维素和卷曲菌毛的RDAR型;而在37 ℃条件下,85.71%的菌株表现为不产EPS的SAW型,提示温度对EPS分泌表型具有显著影响。进一步通过96孔板结晶紫定量法验证,所有菌株在至少一种测试环境条件下均具备生物膜形成能力。在25 ℃有氧培养48小时后,生物膜形成率达到100%;在25 ℃微需氧条件下培养相同时长,生物膜生物量显著增加。基于上述结果,本研究筛选出生物膜形成能力稳定且具代表性的菌株BF 9和BF 15进行后续实验。BF 9和BF 15在不同温度与氧浓度条件下均表现出持续增强的的生物膜光学密度 (OD值) 和活菌计数 (CFU),尤其在25 ℃微需氧培养48小时后生物膜形成能力最为显著。
图为刚果红琼脂上的菌落形态分类:不同形态对应于特定的胞外多糖 (EPS) 分泌模式 (如纤维素和卷曲菌毛)
2. 噬菌体的筛选与生物膜破坏效果
自CECAV噬菌体库中筛选获得三株对婴儿沙门氏菌BF 9和BF 15具有高效裂解活性的噬菌体,其侵染效率 (EOP) 均≥1。其中vB_Si_CECAV_FGS009和vB_CECAV_044可表达解聚酶,提示其具备降解胞外聚合物的能力。采用单一噬菌体及1:1:1混合噬菌体组合 (CKT) 处理48小时成熟生物膜,结果显示37.5%的实验组中OD值显著下降 (p < 0.05),78.13%的实验组中CFU显著降低。具体而言:
在25 ℃有氧条件下,vB_Si_CECAV_FGS017和CKT处理使BF 9生物膜由中等水平减弱至低水平;
在37 ℃有氧条件下,所有噬菌体处理组的CFU均显著降低,其中vB_CECAV_044处理组CFU降幅最高,达4个对数单位;
在37 ℃微需氧条件下,所有噬菌体处理均导致CFU显著减少,但OD值未见显著变化。
扫描电镜 (SEM) 观察进一步证实噬菌体对细菌的裂解作用。经vB_Si_CECAV_FGS017处理后,BF 9菌体长度由1.47 μm增至2.40 μm,表明细胞发生膨大并趋于裂解。

图为BF 9和BF 15在25 ℃条件下经噬菌体处理48小时后形成生物膜的SEM图像
3. 环境条件对噬菌体效果的影响
环境因素显著影响噬菌体对生物膜的清除效率。在温度方面,25 ℃更有利于噬菌体降低OD值,而37 ℃下则更显著减少CFU。就氧浓度而言,有氧条件下vB_Si_CECAV_FGS017对OD值的降低率达50%,而在微需氧条件下,CKT可实现100%的CFU减少率。此外,不同菌株对噬菌体的敏感性存在明显差异,如BF 15在25 ℃有氧条件下仅对vB_Si_CECAV_FGS017和vB_CECAV_044敏感;相比之下,BF 9在多数条件下对多种噬菌体均表现出响应。研究还发现,尽管噬菌体鸡尾酒组合在整体CFU控制方面效果最优,但在某些环境条件下单一噬菌体反而表现出更优的清除效果,表明噬菌体之间可能存在竞争或拮抗作用。
总结与展望
本研究证实,所选噬菌体能够有效破坏婴儿沙门氏菌生物膜,其清除效果受环境条件 (温度、氧浓度)、菌株遗传特性及噬菌体类型共同调控。该结果为噬菌体在家禽养殖场及食品生产链中的实际应用提供了理论依据。一方面,噬菌体可作为传统消毒剂的补充策略,在低温、低氧等易形成生物膜的环节中发挥协同杀菌作用。另一方面,在实际应用中需结合具体环境靶向筛选高效噬菌体或优化鸡尾酒配方,以避免因环境适配性不足导致效果衰减。未来研究可进一步整合噬菌体基因组学与细菌转录组分析,深入解析解聚酶与EPS的分子互作机制,同时拓展更多样的野生菌株和环境参数,以提升噬菌体疗法在生物膜控制中的适用性和稳定性。
原文出自 Antibiotics 期刊:https://www.mdpi.com/3418040
Antibiotics 期刊介绍:https://www.mdpi.com/journal/antibiotics
主编:Nicholas Dixon, University of Wollongong, Australia
期刊内容主要涉及生物化学、化学、遗传学、微生物学和药理学等一般领域的研究。
2024 Impact Factor:4.6
2024 CiteScore:8.7
Time to First Decision:15 Days
Acceptance to Publication:2.6 Days


转载本文请联系原作者获取授权,同时请注明本文来自MDPI开放科学科学网博客。
链接地址:https://wap.sciencenet.cn/blog-3516770-1506100.html?mobile=1
收藏